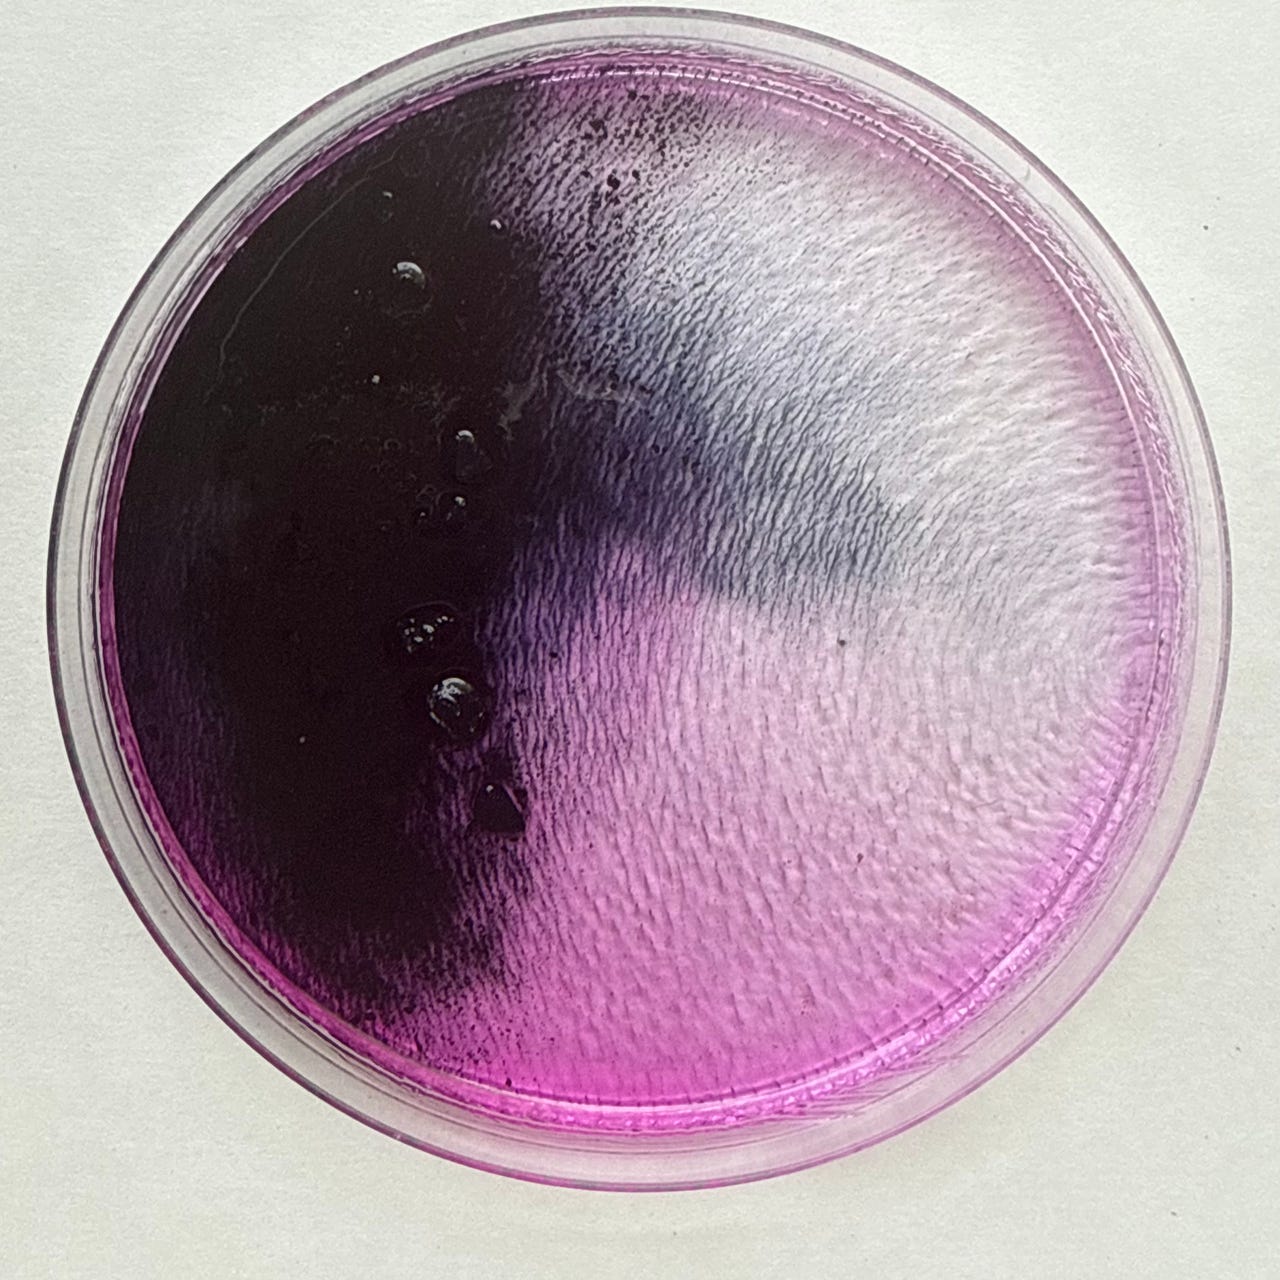
Indigo Crash Course

Bethany Joy's Substack
BethanyCome build a home in a homeless world.
| Platform | Pricing | Only free issues | Publishes | Weekly | |
|---|---|---|---|---|---|
| Issues | 45 | Founded | 5 years ago | Last Issue | 4 months ago |
| Active | |||||
Read this Newsletter
bethanyjoyful.substack.com
Latest Issues
Do Not Hinder Them
When Jesus tells you He will meet you somewhere, pay attention.
“Whoever welcomes one of these little children in my name, welcomes me,” he says in the Gospels (cf. Matthew 18:5, Mark 9:37, and Luke 9:48). And later in the Gospel of Matth...
Hospitality in the Age of AI
My home is a house divided on the subject of AI. My husband finds the various chatbots to be useful tools and also accepts their inevitability as a shaping medium in this brave new world. I, on the other hand, sit at my spinning wheel and r...
Tidings of Comfort and Joy
Last year, I wrote about how Christmas caroling participates in neighborhood rhythms of hospitality. This year, the editors at Plough Magazine invited me to reflect more on this ancient practice. You would honor me if you would check that o...
Hospitality and the Renewal of Vocation
The conflation of “career” and “vocation” is a problem. For the first decade of adulthood, I had the luxury of ignoring this problem; I was one of the privileged few who was able to spend my post-high school years studying a subject that I...
Dreams of hospitality
It’s hard to welcome others when you don’t feel you have much to give.
Even as the heirs of staggering material abundance, we feel the pinch of poverty in other ways: in our stuffed and speeding calendars; in our strength-sapped, careworn...
Key Facts
Related Newsletters
Audience Metrics
Subscribers, engagement, traffic and sponsorship for Bethany Joy's Substack .
| Subscribers | Engagement | 68 | Monthly Web Visits | ||
|---|---|---|---|---|---|
| Accepts Sponsors | Estimated Cost per Ad | ||||
Explore More
Authors
The writers behind this newsletter.
Radical homemaker, renegade PhD. Come build a home in a homeless world.
Frequently Asked Questions
How can I access the email archive for Bethany Joy's Substack ?
You can find recent issues that have been published by Bethany Joy's Substack on Reletter by scrolling up to where it says Latest Issues. Tap on the link for any of the most recent emails or hit More Issues to see older ones.
How many subscribers does Bethany Joy's Substack have?
To see how many people subscribe to Bethany Joy's Substack , simply upgrade your Reletter account. We provide readership numbers and lots of other stats for this newsletter so you can decide if it's worth reaching out to.
How can I advertise in Bethany Joy's Substack ?
Newsletter advertising can be extremely effective when it's done right. Before you pitch Bethany Joy's Substack as a potential sponsor or partner, make sure that you've done your research and checked its newsletter stats with Reletter.
Then, personalize one of our winning pitching templates and send it to the right person using the contact info provided.
How much does it cost to sponsor a publication like Bethany Joy's Substack ?
Newsletter ad rates (or CPM) vary depending on many factors, including industry, number of subscribers, open rate, ad placement and more.
To find out how much an ad will cost, contact Bethany Joy's Substack using the contact information provided and ask for a copy of their media kit.
How can I find newsletters related to Bethany Joy's Substack ?
Scroll up to where it says Related Newsletters to see other publications like Bethany Joy's Substack . You can also search our email newsletter directory to discover other newsletters that cover the topics you're interested in.
How do I contact Bethany Joy's Substack ?
Reletter provides this newsletter's website URL above, where you will often find their contact information. We also provide links to associated social media accounts and pitching templates so you can reach out fast.